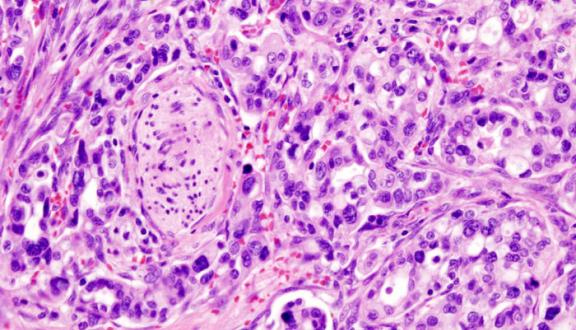

Ettore Meccia

Biologo molecolare e ricercatore presso l'Istituto Superiore di Sanità, si interessa dei meccanismi di base della mutagenesi, della cancerogenesi e in generale della biologia dei tumori, anche in relazione all'effetto di fattori ambientali.
di Ettore Meccia
5 Feb 2026
di Ettore Meccia
5 Ago 2024